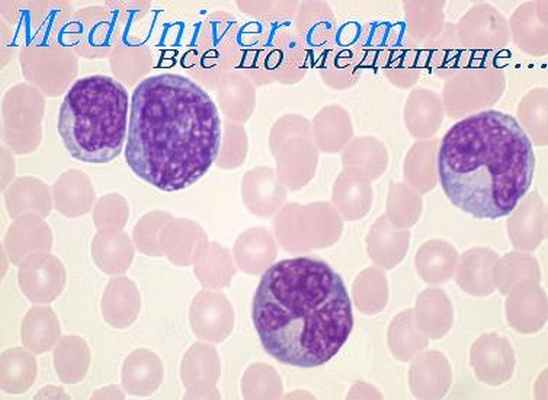
макрофаги

Макрофаги и гранулоциты. Свойства макрофагов
Добавил пользователь Евгений Кузнецов Обновлено: 03.11.2025
Хотя некоторые антигены (АГ) могут непосредственно стимулировать иммунный ответ, Т-клеточно-зависимый приобретенный иммунный ответ обычно требует присутствия АГ-презентирующих клеток (АПК), которые представляют пептиды АГ в комплексе с молекулами МНС (главного комплекса гистосовместимости).
Внутриклеточные антигены (например, вирусы) могут быть преобразованы и представлены рецептором CD8 Т-лимфоцитов любыми ядерными клетками, поскольку все они несут на своей поверхности молекулы МНС I класса. С помощью кодирующих их белков, которые вмешиваются в данный процесс, некоторые вирусы (например, цитомегаловирус) избегают уничтожения.
Внутриклеточные антигены (например, от многих бактерий) должны быть преобразованы в пептид и представлены в комплексе с молекулами МНС II класса на поверхности АПК (которые специализируются на презентации антигенов Т-клеткам) для распознавания CD4 Т-хелперами (Th). Клетками, конститутивно экспрессирующими молекулы ГКГ класса II, и поэтому действующие как так называемые профессиональные АПК, являются:
Дендритные клетки присутствуют в коже (клетки Лангерганса), лимфоузлах и в тканях всего организма. Дендритные клетки в коже – пограничные АПК, они захватывают АГ, доставляют его в локальные лимфоузлы, где активируют Т-лимфоциты. Фолликулярные дендритные клетки – это клетки особой клеточной линии, которые не экспрессируют молекулы МНС II класса и поэтому не представляют АГ TH-клеткам. Они не фагоцитируют, но содержат рецепторы к кристаллизирующемуся фрагменту (Fc) иммуноглобулина (Ig) G и комплементу, что позволяет им связываться с иммунными комплексами и представлять их В-лимфоцитам зародышевых центров вторичных лимфоидных органов.
Моноциты в кровотоке являются предшественниками тканевых макрофагов. Моноциты мигрируют в ткани, где через 8 часов они развиваются в макрофаги под воздействием колоние-стимулирующего фактора макрофагов (М-КСФ), секретируемого различными типами клеток (например, клетками эндотелия, фибробластами). В очагах инфекции активированные Т-клетки секретируют цитокины (например, интерферон-гамма [ИФН-гамма]), которые индуцируют продукцию фактора ингибирования миграции макрофагов, тем самым предотвращая выход макрофагов.
Макрофаги активируются цитокинами (например, ИФН-гаммой, интерлейкином (ИЛ)-4, ИЛ-13) и различными микробными компонентами (например, липополисахаридом). Активированные макрофаги уничтожают внутриклеточные микроорганизмы и секретируют цитокины (например, фактор некроза опухолей-альфа (ФНО-альфа), ИЛ-10. Основываясь на различных профилях экспрессии генов, были идентифицированы подтипы макрофагов (например, М1, М2), которые играют различную роль в усилении или ограничении воспалительного ответа.
Основная функция В-клеток - превращаться в плазматические клетки, которые вырабатывают и секретируют антитела.
Лимфоциты
2-мя важнейшими типами лимфоцитов являются:
В-лимфоциты (которые созревают в костном мозге)
Т-лимфоциты (которые созревают в тимусе)
Основные типы лимфоцитов не различаются с точки зрения морфологии, но имеют разные иммунные функции. Они отличаются друг от друга АГ-специфическими поверхностными рецепторами и другими молекулами клеточной поверхности, называемыми кластерами дифференцировки (CD), которые присутствуют или отсутствуют в определенном клеточном подтипе. Было идентифицировано более 300 CD, многих из которых нет в лимфоцитах, но они находятся в других клетках иммунной системы. CD-молекулы участвуют в клеточной адгезии, клеточной передаче сигналов, в качестве рецепторов Fc-области иммуноглобулинов, в качестве рецепторов для компонентов системы комплемента и других процессах. (Для получения дополнительной информации о молекулах CD см. веб-сайт Human Cell Differentiation Molecules (Молекулы дифференциации клеток человека)). Каждый лимфоцит распознает специфический АГ посредством поверхностных рецепторов.
В-клетки
Составляют от 5 до 15% всех лимфоцитов крови; также присутствуют в костном мозге, селезенке, лимфоузлах, на слизистой оболочке лимфоидных тканей.
После случайной реаранжировки генов, кодирующих иммуноглобулин (lg), В-лимфоциты в совокупности способны распознавать практически бесконечное число уникальных АГ. Перегруппировка генов последовательно происходит во время развития В-лимфоцитов в красном костном мозге. Процесс начинается с направленной стволовой клетки, которая проходит стадии про-В- и пре-В-лимфоцитов, и завершается образованием незрелого В-лимфоцита. В этот момент любые клетки, взаимодействующие с собственными АГ (аутоиммунные клетки), удаляются из популяции незрелых В-лимфоцитов путем инактивации (анергии) или апоптоза. Элиминация таких клеток гарантирует, что иммунная система с меньшей вероятностью распознает эти антигены как чужеродные (иммунная толерантность). Неудаленные В-лимфоциты (то есть, взаимодействовавшие не с собственными АГ организма) могут продолжить развитие до стадии зрелого молодого В-лимфоцита, покинуть красный костный мозг и переместиться в периферические лимфоидные органы, где может произойти их встреча с АГ.
Их ответ на антигенпроисходит в 2 этапа:
Первичный иммунный ответ: когда зрелые молодые В-лимфоциты впервые сталкиваются с АГ, эти клетки претерпевают бласт-трансформацию, клональную пролиферацию и дифференцировку в клетки памяти, которые отреагируют на такой же АГ в будущем, или в зрелые АТ-продуцирующие плазмоциты. До продукции АТ существует латентный период в несколько дней. Затем, продуцируются только IgM. После взаимодействия с Т-лимфoцитами в В-лимфоцитах может иметь место дальнейшая перегруппировка генов lg, что переключает синтез на IgG, IgA или IgE. Таким образом, при первичной встрече с АГ иммунный ответ развивается медленно и первоначально обеспечивает ограниченную иммунную защиту.
Вторичный (анамнестический или бустерный) иммунологический ответ: когда В-клетки и TH -клетки памяти повторно подвергаются воздействию АГ, В-клетки быстро пролиферируют, дифференцируются в зрелые плазмоциты и быстро продуцируют большое количество АТ (главным образом, IgG, т. к. Т-лимфоциты индуцируют переключение синтеза этого изотипа). АТ поступают в кровь и другие ткани, где могут взаимодействовать с АГ. Таким образом, после повторной встречи с АГ иммунный ответ более быстрый и эффективный.
Т-клетки
Источником развития Т-клеток являются стволовые клетки костного мозга, которые мигрируют в тимус, где происходит процесс строгой селекции. Существует 3 основных типа Т-лимфоцитов:
При селекции Т-клетки, которые способны реагировать на антиген в комплексе с молекулами ГКГ собственного организма (или сильно реагирующие на собственные молекулы ГКГ независимо от представленного АГ), элиминируются путем апоптоза, ограничивая вероятность аутоиммунных процессов. Остаются только Т-лимфоциты, опознающие чужеродный АГ, связанный с молекулами МНС собственного организма; они покидают тимус, выходят в периферическую кровь и лимфоидные ткани.
Более зрелые Т-лимфоциты экспрессируют CD4 или CD8, а также АГ-связывающие lg-подобные рецепторы, называемые Т-клеточными рецепторами (РТК). Существует 2 типа РТК:
Альфа-бета РТК: состоят из РТК альфа- и бета-цепей; присутствуют на большинстве Т-лимфоцитов
Гамма-дельта РТК: состоят из РТК гамма- и дельта-цепей; присутствуют на небольшой популяции Т-лимфоцитов
Гены, кодирующие РТК, как и гены Ig, перестраиваются; в результате этого достигается определенная специфичность и аффинность к АГ. Большинство Т-клеток (у которых альфа-бета-РТК) распознают антиген-производный пептид, представленный молекулами MHC на антигенпрезентирующих клетках. Гамма-дельта Т-клетки распознают белок антигена напрямую или распознают липид антигена, выделяемый МНС-подобной молекулой, называемой CD1. Как и у В-лимфоцитов, число специфичных связей у Т-лимфоцитов практически неограниченно.
Для активации альфа-бета Т-лимфоцитов необходимо связывание РТК с антиген-МНС (см. рисунок Модель двух сигналов для активации Т-лимфоцитов [ Two-signal model for T cell activation Модель двух сигналов для активации Т-лимфоцитов ]) . Также требуется взаимодействие со вспомогательными молекулами (например, CD28 на Т-клетках взаимодействует с CD80 и CD86 на антигенпрезентирующих клетках); в противном случае Т-лимфоцит останется неактивированным или погибнет в результате апоптоза. Некоторые вспомогательные молекулы (например, CTLA-4 [цитотоксический Т-лимфоцитарный антиген 4] на Т-клетке, взаимодействующий также с CD80 и CD86 на антигенпрезентирующей клетке, PD-1 [белок запрограммированной клеточной смерти 1] на Т-клетке, который взаимодействует с PD-L1 [лиганд белка запрограммированной клеточной смерти 1] на антигенпрезентирующей клетке) ингибируют предварительно активированные Т-клетки и, таким образом, ослабляют иммунный ответ. Такие молекулы, как CTLA-4 и PD-1, и их лиганды, называются контрольными точками, поскольку они подают сигнал о прекращении активации Т-лимфоцитов. Таким образом, раковые клетки, которые экспрессируют молекулы контрольных точек, могут быть защищены от иммунной системы путем ограничения активности опухолеспецифических Т-клеток.
Моноклональные антитела, которые нацелены на молекулы контрольных точек как Т-клеток, так и опухолевых клеток (так называемые ингибиторы контрольных точек – см. таблицу Клиническое использование некоторых иммунотерапевтических агентов Некоторые иммунотерапевтические препараты для клинического применения ) используются для предотвращения подавления противоопухолевых иммунных реакций и эффективного лечения некоторых резистентных до настоящего времени типов раковых заболеваний и усиления противоопухолевого ответа. Однако, поскольку молекулы контрольных точек также участвуют в предотвращении других типов иммунного ответа (таких как самостоятельные аутоиммунные реакции), ингибиторы контрольных точек могут вызывать тяжелые иммунные воспалительные и аутоиммунные реакции (как системные, так и органоспецифические) или усугублять аутоиммунные нарушения.
Полиморфизм гена CTLA-4 ассоциирован с некоторыми аутоиммунными патологиями, в том числе, с болезнью Грейвса ЭтиологияМодель двух сигналов для активации Т-лимфоцитов
Альфа (α) и бета (β) цепи Т-клеточного рецептора (РТК) связываются с комплексом антиген (АГ)-главный комплекс гистосовместимости (МНС) на поверхности антиген-презентирующей клетки (АПК), и рецептор CD4 или CD8 вступает во взаимодействие с МНС. Оба эти действия через дополнительные цепи CD3 стимулируют Т-лимфоциты (1-й сигнал). Тем не менее, без 2-го сигнала (сочетанная активация) Т-лимфоцит останется анергичным или толерантным к АГ.
РТК структурно гомологичен рецептору В-клеток; α и β (или гамма [γ] и дельта [δ] ) цепи содержат постоянную (C) и вариабельную (V) области. (1) = 1-й сигнал; (2) = 2-й сигнал.
Макрофаги и гранулоциты. Свойства макрофагов
Макрофаги и гранулоциты. Свойства макрофагов
В последнее время внимание исследователей привлекла к себе роль фагоцитарных клеток в иммунном ответе, в частности их взаимодействие с Т- и В-клетками. Большинство исследований проводилось па экспериментальных животных, однако сейчас изучается вопрос о том, приложила ли эта информация к болезням человека. Единственную в своем роде возмояжность открывают перед нами заболевания легких, когда альвеолярные макрофаги можно без риска получить как от здоровых, так и от больных путем промывания легких через бронхоскоп с волоконной оптикой.
Как гранулоциты, так и макрофаги образуются в костном мозге. Предшественниками гранулоцитов являются миолобласт, промиелоцит и миелоцит, а предшественниками макрофага — миобласт и промоноцит. Основная функция сегментоядерной клетки заключается в том, чтобы уничтожать бактерии путем фагоцитоза и внутриклеточного умерщвления под воздействием протеолитических (лизосомальных ферментов). Этой функции способствует прилипание антител (опсонинов) и комплемента (иммунное прилипание) к клеточной поверхности.
Функция макрофагов более сложна. Макрофаги поглощают самые разнообразные инородные вещества, включая бактерии, вирусы, грибы, простейшие, эритроциты, клеточный детрит, комплексы антигенов с антителами, а также вдыхаемую органическую и неорганическую пыль. Они участвуют также в защите против злокачественных опухолей [Lohmann-Mathes, Fisher, 1974] и в образовании антител благодаря соответствующему предъявлению антигена [Mackaness, 1970].
Особым свойством макрофага является его способность адаптировать свою внутриклеточную активность при взаимодействии с сенсибилизированными Т-клетками, которые могут активировать макрофаги, вероятно, путем секреции лимфокинов, в результате чего увеличиваются содержание в них ферментов и их функциональная активноесть [Mackaness, 1970]. В отличие от сегменто-ядерного лейкоцита макрофаг может оказывать свое цитотоксическое действие отчасти и снаружи, например на злокачественные опухоли.
Если активность макрофагов блокируется массивным поглощением такого неперевариваемого материала, как окись кремния, углерод и асбест, то не только нарушается поглощение других материалов, включая микробы, но и могут пострадать нормальное действие Т-клеток и образование антител.
Из этого краткого описания можно видеть, что тканевый макрофаг играет центральную роль в иммунном ответе. Он перерабатывает частиковый антиген так, чтобы соответствующим образом предъявить его и вызвать стимуляцию Т-клеток, которые в свою очередь помогают стимулированию В-клеток и образованию ими антител. Сенсибилизированные Т-клетки могут также активировать макрофаги, усиляя их активность для защиты организма.
Информация на сайте подлежит консультации лечащим врачом и не заменяет очной консультации с ним.
См. подробнее в пользовательском соглашении.
Макрофаги и гранулоциты. Свойства макрофагов
1 ГБОУ ВПО «Саратовский государственный медицинский университет им. В.И. Разумовского Минздрава России»
1. Аллергология и иммунология, клинические рекомендации для педиатров / Под ред. А.А. Баранова и Р.М. Хаитова. – М.: М-Студио. – 248 с.
2. Гематология / Рукавицын О.А., Павлов А.Д., Морщакова Е.Ф. и др. Под ред. О.А. Рукавицына. – Изд–во СПб.: ООО «Д.П.», 2007. – 912 с.
3. Гематологический атлас. С. Луговская, М.Е. Почтар. 3-е издание. – Москва – Тверь. ООО «Изд-во Триада», 2011. – 368 с.
4. Драпник Г.Н. Клиническая иммунология и аллергология. – М. ООО «Медицинское информационное агентство», – 2003. – 604 с.
5. Зайчик А.Ш. Механизмы развития болезней и синдромов // А.Ш. Зайчик, Л.П. Чурилов. – СПб.: ЭЛБИ, 2002. – Т. 3. – 507 с.
6. Нормальная физиология: учебник [Н.А. Агаджанян, Н.А. Барабаш, А.Ф. Белов и др.] / Под ред. проф. В.М. Смирнова. – 3-е изд. – М.: Издательский центр «Академия», 2010. – 480 с.
8. Типовые реакции иммунной системы на действие антигенов–аллергенов / Под общей ред. проф. Чесноковой Н.П. – Изд–во Саратов. мед. ун-та. Саратов, 2014. – 154 с.
9. Физиология человека / В.Ф. Киричук, О.Н. Антипова, Н.Е. Бабиченко, В.М. Головченко, Е.В. Понукалина, И.В. Смышляева, Л.К. Токаева / Под ред В.Ф. Киричука. – 2-е изд. – Изд-во Саратовского медицинского университета. – 2009. – 343 с.
12. Abbas A.K. Diseases of immunity / Robbins and Cotran pathologic basis of disease. – 7th ed. / Editet by V. Kumar, A.K. Abbas, N. Fausto. – Philadelphia, Pennsylvania. Elserier, 2005. – P. 193–267.
Антигенперерабатывающие и антигенпрезентирующие клетки
Мононуклеарная система фагоцитов включает в себя промоноциты костного мозга и их предшественников, моноциты крови и тканевые макрофаги.
Дифференцировка моноцитов из монобластов происходит в костном мозге в течение 5 дней, после чего они сразу выходят в кровоток, не формируя, в отличие от гранулоцитов, костномозговой резерв. Небольшая часть моноцитов трансформируется в макрофаги костного мозга.
В крови человека имеются маргинальный пул моноцитов, примыкающий к сосудистой стенке, и циркулирующий пул.
Непринимающий участие в циркуляции маргинальный пул в 3,5 раза больше, чем пул циркулирующих моноцитов.
В периферической крови моноциты составляют от 1 до 10 % всех лейкоцитов, что соответствует абсолютному количеству, равному 80–600 клеткам в 1 мм3 у взрослых. Моноциты циркулируют в крови от 1,5 до 4,5 суток, а затем покидают ее и эмигрируют в ткани.
Тканевой пул моноцитов в 25 раз превышает внутрисосудистый пул. В тканях происходит трансформация моноцитов в тканевые макрофаги. Сроки жизни тканевых макрофагов составляют 60 дней и более. Наибольшее количество макрофагов содержится в печени (56,4 %) , в легких (14,9 %) , селезенке (15 %) , перитонеальной полости (7,6 %). Тканевым макрофагам отводится ведущая роль в переработке антигена, образовании высокоиммуногенных фракций антигена, индукции иммунного ответа.
Антигенперерабатывающие клетки, или профессиональные фагоциты (А–клетки), включают в себя фиксированные макрофаги печени, костного мозга, селезенки, лимфатических узлов, центральной нервной системы, а также остеокласты, альвеолярные и перитонеальные макрофаги, макрофаги плевральной и перикардиальной областей, эпителиоидные и гигантские многоядерные клетки очагов воспаления.
Основными функциями антигенперерабатывающих клеток являются фагоцитоз и уничтожение различных объектов, к числу которых относятся микроорганизмы, иммунные комплексы, опухолевые клетки, вирусинфицированные клетки, а также поврежденные, дегенерирующие в процессе апоптоза клетки.
Фагоцитоз, обеспечиваемый антигенперерабатывающими клетками, осуществляется в виде классических стадий: приближения фагоцита к фагоцитируемому объекту, аттракции, поглощения объекта фагоцитом, умерщвления (киллинга) жизнеспособных объектов, переваривания нежизнеспособных объектов.
Процессы киллинга во всех антигенперерабатывающих клетках обеспечиваются при участии кислородзависимых и кислороднезависимых бактерицидных систем. Кислородзависимые системы обеспечиваются миелопероксидазой, продуктами дыхательного взрыва, возникающего при активации фагоцитов: Н2О2, супероксидным анион-радикалом, гидроксильным радикалом, синглетным кислородом, галогенами.
Кислороднезависимые системы включают лизоцим, лактоферрин, щелочную фосфатазу, катионные белки, кислую среду фагосом.
При утрате жизнеспособности патогенных агентов антигенперерабатывающие клетки обеспечивают их переваривание за счет выделения в фагосому содержимого лизосом. В процессе слияния фагосомы и лизосомы формируется фаголизосома, где проявляют разрушающее действие различные гидролитические ферменты: протеазы, амилазы, липазы, фосфолипазы, эластазы, коллагеназы, ДНК-азы, РНК-азы, глюкозидазы и др.
Общими свойствами профессиональных фагоцитов, или антигенперерабатывающих и представляющих клеток, являются секреция биологически активных соединений на фоне антигенной стимуляции, а также представление антигенов лимфоцитам.
К профессиональным антигенпредставляющим клеткам, помимо моноцитов и А–клеток, относят клетки Лангерганса, дентритные клетки – ДК, интердигитирующие клетки тимуса, фолликулярные дендритные клетки зародышевых центров лимфатических узлов, которые несут конституциональные антигены MHC.
Касаясь локализации антигенпредставляющих клеток, следует отметить, что клетки Лангерганса локализованы в супрабазальном слое эпидермиса, составляя до 2 % всех эпидермальных клеток, а также в эпителии слизистой полости рта, пищевода, легких, влагалища, шейки матки, конъюнктивы. В небольшом количестве клетки Лангерганса выявляются в тимусе, лимфатических узлах, селезенке.
Клетки Лангерганса являются основными клетками, регулирующими интенсивность иммунного ответа в коже. Они относятся к линии дендритных клеток в связи с их способностью образовывать длинные цитоплазматические отростки, посредством которых происходит контакт с другими клетками.
Другой разновидностью антигенпредставляющих клеток являются фолликулярные дендритные клетки, локализующиеся в зародышевых центрах и первичных лимфоидных фолликулах лимфоузлов, а также селезенке.
Интердигитирующие клетки, а также клетки Лангерганса располагаются в паракортикальных зонах лимфоузлов и соответствующих Т-зависимых зонах селезенки, миндалин, мозговом веществе тимуса. В небольшом количестве они содержатся практически во всех органах и тканях.
ДК вторичных лимфоидных органов представлены несколькими субпопуляциями, отличающимися по степени экспрессии СД18. Различают незрелые ДК, а также зрелые ДК: ДК1 и ДК2, несущие различные хемокины и обеспечивающие, соответственно, дифференцировку Th0 в Th1 и Th2. Костномозговые ДК способны вызвать как Th1, так и Th2.ответы.
К числу непрофессиональных антигенпредставляющих клеток могут быть отнесены также В-лимфоциты, эндотелий сосудов, а также полиморфноядерные лейкоциты, кератиноциты, эозинофилы, тучные клетки, которые несут только индуцированные молекулы MHC.
Самыми эффективными антигенпредставляющими клетками являются дендритные клетки, способные представить антиген в первичном иммунном ответе. Источником происхождения дендритных клеток являются стволовая кроветворная клетка и, возможно, общий для Т- и В-лимфоцитов предшественник. Дендритные клетки обеспечивают индукцию иммунного ответа на экзогенные и эндогенные антигены.
Дендритные клетки первыми связывают антигенные вещества, проникая через барьер кожи, возможно, и слизистых; прочно фиксируют антиген на своей поверхности; обеспечивают неглубокий эндоцитоз и частичное ферментативное расщепление антигена.
Сконцентрировав антиген на клеточной мембране, дендритные клетки поступают в циркуляцию, затем распространяются в лимфатические узлы для представления и распознавания антигена лимфоцитами.
За короткий промежуток времени эмиграции дендритных клеток в лимфоидные органы на их мембране в высокой концентрации экспрессируются молекулы МНС-II или МНС-I.
Профессиональный фагоцит- макрофаг способен эффективно присоединять комплекс антиген-антитело за счет наличия специализированных рецепторов к Fс-фрагменту иммуноглобулинов. Фрагменты расщепления антигена из поглощенного комплекса макрофаг экспонирует на клеточной мембране в комплексе с молекулами МНС –IМНС-II, т.е. как и классические дендритные антигенпредставляющие клетки.
Следует отметить, что Т-лимфоциты способны лишь к «двойному» распознаванию пептидных антигенов только при условии их укомплектованности на поверхности клеточной мембраны антигенпредставляющих клеток с собственными молекулами клеточной мембраны, называемыми молекулами главного комплекса гистосовместимости (МНС I или II класса). За это открытие ученые P. Doherty и R. Zinkernagel, 1996 г., были удостоены Нобелевской премии по физиологии и медицине.
В-лимфоциты в роли антигенпредставляющих клеток способны уловить иммуноглобулиновым рецептором мембраны низкие дозы растворимых антигенов, особенно при повторной антигенной стимуляции.
Эндотелиальные клетки могут выполнять антигенпредставляющую функцию в зоне инфекционного воспаления, т.е. в месте проникновения антигена-аллергена.

Схема участия моноцитарно-макрофагальной системы крови и тканей в механизмах индукции иммунного ответа на корпускулярные антигены-аллергены
Основными антигенпредставляющими клетками являются дендритные клетки Лангерганса, фолликулярные дендритные клетки зародышевых центров лимфатических узлов, интердигитирующие клетки тимуса.
Касаясь значимости клеток мононуклеарной фагоцитирующей системы в развитии межклеточного взаимодействия на фоне антигенной стимуляции, необходимо отметить не только их фагоцитарную и антигенпредставляющую функции, но и способность к продукции комплекса биологически активных соединений – монокинов.
Монокины – гетерогенная группа соединений с различной биологической активностью. К числу монокинов относятся следующие группы веществ:
Медиаторы воспаления и иммуномодуляции (интерлейкин 1, фактор некроза опухоли, интерферон, лизоцим, фактор активации нейтрофилов, компоненты системы комплемента С1, С2, С3, С5, а также интерлейкины – 3, 6, 8, 10, 12, 15).
Факторы свертывающей системы крови, активаторы и ингибиторы фибринолиза (активатор плазминогена, ингибиторы плазминогена и плазмина, V, VII, IX, Х плазменные факторы свертываемости крови).
Факторы роста, в частности, различные колониестимулирующие факторы, активизирующие гемопоэз в костном мозге, фактор роста фибробластов.
Моноциты и тканевые макрофаги являются ведущими клетками иммунного ответа организма, обеспечивая переработку антигенов и их презентацию (особенно при вторичном иммунном ответе) Т-хелперам. Подобная презентация необходима для запуска иммунного ответа на многие Т-зависимые антигены.
Связь между Т-хелперами и макрофагами обеспечивается при участии адгезивных молекул, синтез которых, в свою очередь, зависит от интенсивности продукции макрофагами ИЛ-I,ИЛ-6,ФНО (рисунок).
Резюмируя вышеизложенное, следует заключить, что моноциты периферической крови, трансформируясь в тканевые макрофаги по мере эмиграции за пределы сосудистого русла, обеспечивают многогранные функции, включающие не только фагоцитоз и элиминацию клеток, несущих генетически чужеродную информацию, но и индукцию иммунного ответа со стороны Т- и В-систем лимфоцитов, а также развитие синдрома системного воспалительного ответа за счет активации синтеза цитокинов с полимодальным локальным и системным действием.
Макрофаги и гранулоциты. Свойства макрофагов
Среди инфильтрирующих опухоль воспалительных клеток встречаются многочисленные клеточные фенотипы, включая макрофаги, дендритные клетки (дк), супрессирующие клетки миелоидного происхождения, гранулоциты и т-лимфоциты. Несмотря на то, что многие клетки морфологически похожи, они функционально гетерогенны и по-разному влияют на рост опухоли и ее метастазирование.
Снижение количества и функции макрофагов может облегчать метастазирование. Это открытие согласуется с тем наблюдением, что введение активированных макрофагов тормозит рост первичной опухоли и препятствует метастазированию. Однако макрофаги также стимулируют неоангиогенез, облегчая рост опухоли и метастазирование, так что обширная инфильтрация опухоли макрофагами является индикатором неблагоприятного прогноза. Инфильтрация опухоли контролируется хотя бы частично свойствами первичной опухоли, что может регулировать функции макрофагов, такие как цитотоксичность опухольассоциированных макрофагов (tam), которые могут различаться в зависимости от происхождения опухоли.
Подобно макрофагам дк содержат многочисленные субпопуляции с различными фенотипами и функциями. В отличие от макрофагов, инфильтрация опухоли дк является показателем позитивного прогноза, поскольку они обладают большой способностью стимулировать иммунный ответ наивных т-клеток на опухоль. Подтип инфильтрирующих дк и его пространственная локализация в паратуморальном участке или участках некроза влияет на оценку прогноза. Кроме их способности стимулировать ответ т-клеток, дк могут также отклонять иммунный ответ либо в сторону иммуносупрессии, либо усиления иммунитета и эффекторного ответа [1].
Инфильтрировать опухоли могут также супрессирующие клетки миелоидного происхождения (mdscs). Эти клетки обладают высокой способностью к иммуносупрессии и могут дифференцироваться у мышей, обеспечивая потенциально полезные для терапии макрофаги и дк. Mdscs, так же, как и tams, могут тормозить функции дк и вызывать апоптоз т-клеток [2, 3].
Инфильтрация т-клетками обычно являются фактором, предполагающим позитивный клинический исход. Однако анализ подтипов продемонстрировал, что инфильтрация cd8+ t клетками является позитивным индикатором, а инфильтрация cd4+ t регуляторными (treg) клетками является негативным прогностическим индикатором. На течение заболевания также влияют взаимодействия между натуральными киллерами т-клетками (нкт) i типа и cd4+/cd25+ t-регуляторными клетками.
Натуральные киллеры т-клетки являются т-клетками с рецепторами tcr и cd3, но также имеют и рецепторы натуральных киллеров (нк) и другие маркеры, позволяющие им отвечать как эффекторам врожденной иммунной системы и уничтожать клетки подобно нк-клеткам. Нкт-клетки, быстро продуцируя цитокины в ответ на опухоль, могут изменять последующий адаптивный иммунный ответ стандартных cd4+ t-клеток. Нкт-клетки могут отвечать на микробную инфекцию быстрее, чем обычные т-клетки [4]. Нкт-клетки распознают гликолипидные антигены микроорганизмов [5]. Существует два типа нкт, которые не только имеют противоположные функции (усиление и подавление иммунитета), но и регулируют работу друг друга. Действуя на баланс между двумя этими типами нкт, можно повлиять на исход инфекционного, аутоиммунного заболевания и злокачественного новообразования. Th1цитокины связаны с защитным ответом, тогда как th2-цитокины связаны с подавлением противоопухолевого иммунитета. Защитный эффект нкт-клетки не обязательно основан на их литической активности и прямом лизисе опухолевых клеток, но на их продукции ifn и тем самым рекрутировании нк клеток и cd8+ t-клеток, а также на активации дк, которые начинают продуцировать il-12 [5].
Следовательно, не только количество инфильтрирующих клеток является важнейшим для клинического исхода, но и специфический подтип. Манипуляции с данными клетками могут также обеспечить значительную терапевтическую активность [6]. Изучение взаимодействий между различными клетками, инфильтрирующими опухоль, а также механизма избегания иммунного надзора позволит создать новые пути биотерапии опухолей.
Макрофаги и гранулоциты. Свойства макрофагов
Цитокины - белки гл. обр. активированных клеток иммунной системы, обеспечивающие межклеточные взаимодействия. К цитокинам относятся интерфероны (ИНФ), интерлейкины (ИЛ), хемокины, факторы некроза опухоли (ФНО), колониестимулирующие факторы (КСФ), факторы роста. Цитокины действуют по эстафетному принципу: воздействие цитокина на клетку вызывет образование ею других цитокинов (цитокиновый каскад).
Различают интракринный, аутокринный, паракринный и эндокринный механизмы действия цитокинов.
1. Интракринный механизм - действие цитокинов внутри клетки-продуцента; связывание цитокинов со специфическими внутриклеточными рецепторами.
2. Аутокринный механизм - действие секретируемого цитокина на саму секретирующую клетку. Например, интерлейкины-1, -6 -18, ФНОα являются аутокринными активирующими факторами для моноцитов/макрофагов.
3. Паракринный механизм - действие цитокинов на близкорасположенные клетки и ткани. Например, ИЛ-1, -6 -12 и -18, ФНОα, продуцируемые макрофагом, активируют Т-хелпер (Th0), распознающий антиген и МНС макрофага (Схема аутокринно-паракринной регуляции иммунного ответа).
4. Эндокринный механизм - действие цитокинов на расстоянии от клеток-продуцентов. Например, ИЛ-1, -6 и ФНОα, помимо ауто- и паракринных воздеиствий могут оказывать дистантное иммунорегуляторное действие, пирогенный эффект индукцию выработки белков острой фазы гепатоцитами, симптомы интоксикации и мультиорганные поражения при токсико-септических состояниях.
| Аутокринно-паракринная регуляция иммунного ответа |
Интерлейкины (ИЛ) - цитокины, ответственные за межклеточные взаимодействия между лейкоцитами. Описано около 20 интерлейкинов.
Факторы некроза опухоли . Различают: собственно фактор некроза опухоли (ФНО), или ФНОα лимфотоксины, или ФНОβ. ФНОα продуцируется макрофагами, а также тучными клетками и лимфоцитами. Он обусловливает развитие токсического шока и кахексии (старое название кахектин), индуцирует острофазные белки и стимулирует ангиогенез. Может индуцировать апоптоз. Способен вызывать геморрагический некроз ряда опухолей. ФНОα продуцируется Т- и В-лимфоцитами, обладает аналогичным действием.
Интерфероны - гликопротеины, вырабатываемые клетками в ответ на вирусную инфекцию и другие стимулы. Блокируют репликацию вируса в других клетках и участвуют во взаимодействии между клетками иммунной системы. Различают две серологические группы интерферонов: I типа - ИНФ-α и -β и II типа - ИФН-γ. Интерфероны I типа оказывают противовирусные и противоопухолевые эффекты, в то время как интерферон II типа регулирует специфический иммунный ответ и неспецифическую резистентность.
ИНФ-α и ИНФ-β отличаясь по структуре и клеткам-продуцентам, обладают практически одинаковым механизмом действия. В норме ИНФ-α продуцируется мононуклеарными фагоцитами (отсюда одно из названий - "лейкоцитарный ЛФН"), а ИНФ-β - фибробластами ("фибробластный ИФН") . Под воздействием микроба секретируются многими клетками. Усиливают продукцию ИФН пирогеиное действие ИЛ-1 и понижение рН в межклеточной жидкости на фоне повышения температуры. Защитное действие ИНФ I типа реализуется посредством ингибирования репликации РНК или ДНК под воздействием олигоаденилат-синтетазы, которую продуцируют интерферон-содержащие клетки. ИНФ I типа, связываясь со здоровыми клетками, защищает их от вирусов. Антивирусное действие ИНФ I типа может обусловливаться и тем, что он способен угнетать клеточную пролиферацию, препятствуя синтезу аминокислот, например триптофана. Этот механизм, а также способность индуцировать програмированную клеточную гибель некоторых опухолей лежат в основе противоопухолевого действия ИФН I типа. Кроме того, ИНФ I типа усиливает литическое действие нормальных киллеров на клетки-мишени, в том числе трансформированные клетки, индуцирует экспрессию антигенов МНС I и, наоборот, подавляет формирование тех же антигенов МНС II.
ИФН-γ ("иммунный ИФН") продуцируется Т-лимфоцитами и NK. Стимулирует активность Т- и В-лимфоцитов, моноцитов/макрофагов и нейтрофилов. Усиливает экспрессию молекул МНС I, МНС II. Стимулирует дифференцировку ThO в Thl. Иммунный ИФН вместе со своим антогонистом ИЛ-4 поддерживает баланс Thl/Th2. Помимо этого, ИФН-γ регулирует апоптоз целого ряда нормальных, а также некоторых инфицированных и трансформированных клеток. Так, он индуцирует програмированную клеточную гибель активированных макрофагов, кератиноцитов, гепатоцитов, клеток костного мозга, эндотелиоцитов и подавляет апоптоз периферических моноцитов и герпес-инфицированных нейронов.
Колониестимулирующие факторы (КСФ) - цитокины, регулирующих деление, дифференцировку костно-мозговых стволовых клеток и предшественникон клеток крови. Кроме того, они могут стимулировать дифференцировку и функциональную активность некоторых клеток вне костного мозга.
Гранулоцитарный КСФ (Г-КСФ) продуцируется в основном макрофагами, а также фибробластами. Стимулирует деление и дифференцировку стволовые клеток, в некоторой степени усиливает активность нейтрофилов и эозинофилов.
Макрофагальный КСФ (М-КСФ) вырабатывается моноцитами, в меньшей степени эндотелиальными клетками и фибробластами. Активирует пролиферации предшественников макрофагов в костном мозге.
Гранулоцитарно-макрофагальный КСФ (ГМ-КСФ) продуцируется макрофагами И Т-лимфоцитами, а также фибробластами и эндотелиоцитами. Стимулирует деление и дифференцировку предшественников гранулоцитов и макрофагов, активирует функцию макрофагов и гранулоцитов, пролиферацию Т-клеток. Участвует в стимуляции дифференцировки кроветворных предшестенников Е антигенпрезентирующие дендритные клетки.
Хемокины - низкомолекулярные цитокины, ответственные за хемотаксис клеток (привлекают в очаг воспаления лимфоциты и лейкоциты).
Читайте также:
